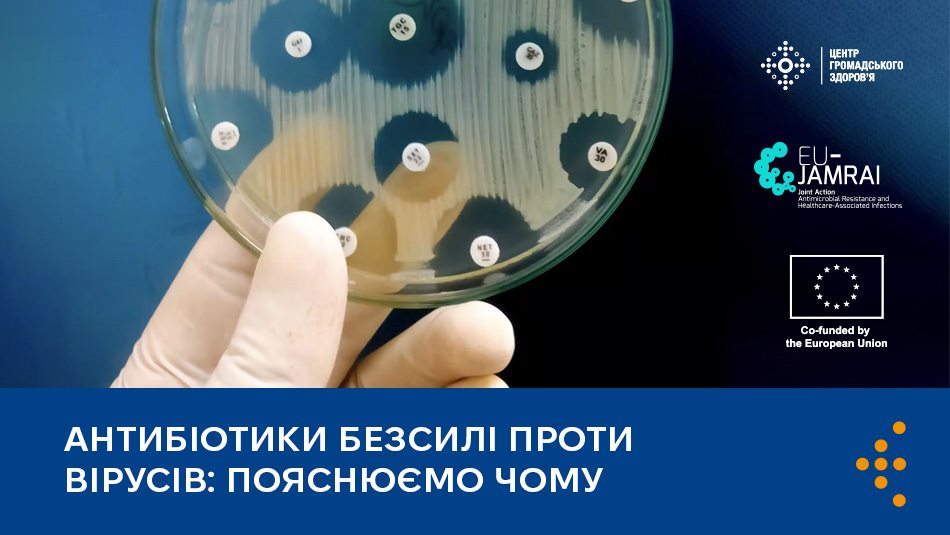

Антибіотики безсилі проти вірусів: пояснюємо чому
В Україні розпочався сезон ГРВІ — час, коли люди частіше хворіють на грип, COVID-19 та інші респіраторні вірусні захворювання. Водночас досі поширене хибне уявлення, що їх можна швидко й ефективно вилікувати антибіотиками навіть без призначення лікаря.
Центр громадського здоров’я пояснює, чому це не так і які можливі наслідки.
1. Гострі респіраторні вірусні інфекції спричиняють ВІРУСИ, а антибіотики діють виключно на БАКТЕРІЇ. Лікування ГРВІ антибіотиками не дасть очікуваного результату, навпаки — може спричинити серйозні ускладнення: шлунково-кишкові розлади, порушення роботи нирок і печінки.
2. Прийом антибіотиків, коли до цього немає показань, може знизити їхню ефективність у майбутньому. Хвороботворні бактерії з часом адаптуються до антибіотиків та стають «загартованішими» до них. Тобто в таких бактерій розвивається антибіотикорезистентність. Коли такі бактерії не реагують на лікування антибіотиками, лікарям тяжче успішно лікувати інфекційні хвороби, в тому числі небезпечні (бактеріальна пневмонія, туберкульоз, сепсис). Антибіотикорезистентність створює додаткове навантаження на медичну систему в Україні під час війни.
3. У кишківнику людини може порушитися здоровий баланс бактерій. Це може спричинити розлади травлення й ослаблення імунітету, а також підвищити ризик інфікування бактерією Clostridium difficile, яка виробляє небезпечні токсини і може призвести до смерті.
4. Від ГРВІ не завжди потрібні ліки. Легкі застуди (нежить, біль у горлі, чхання, загальне погіршення самопочуття, легке підвищення температури тіла до 38℃) не завжди вимагають використання лікарських засобів. Достатньо відпочивати і пити багато води.
5. Тільки лікар може призначати антибіотики й лише у разі підтвердження або обґрунтованої підозри на бактеріальну природу інфекції.
Чотири прості й перевірені поради, як уберегтися від ГРВІ
Дотримання таких рекомендацій допоможе вам уникнути інфікування ГРВІ та убезпечити своїх рідних.
1. Вакцинуйтеся від грипу раз на сезон. Щорічне щеплення допомагає уникнути тяжкого перебігу хвороби та ускладнень. Особливо важливо вакцинуватися людям старшого віку, дітям від 6 місяців, вагітним, людям із хронічними хворобами, а також медикам, освітянам, військовим та іншим, які щодня контактують із великою кількістю людей.
Щеплення проти грипу можна зробити звернувшись до свого сімейного лікаря та придбавши вакцину в аптеці.
2. Вакцинуйтеся проти COVID-19. Людям, які раніше не щепилися, слід отримати одну дозу вакцини. Це безплатно.
Додаткові щеплення кожні 6–12 місяців рекомендовані людям із підвищеним ризиком тяжкого перебігу хвороби та професіоналам, які часто контактують із людьми у своїй роботі.
Вагітним рекомендують вакцинуватися у кожну вагітність.
Щоб отримати щеплення, зверніться до свого сімейного лікаря або в найближчий заклад охорони здоров’я. Станом на жовтень 2025 року держава забезпечена достатньою кількістю вакцини від COVID-19.
3. Дотримуйтеся правил особистої гігієни:
- мийте руки з милом щонайменше 30 секунд, особливо після повернення додому, контакту з поверхнями у громадських місцях;
- використовуйте антисептики зі вмістом спирту не менше 70%;
- коли кашляєте або чхаєте, прикривайте рот і ніс згином ліктя або серветкою (яку слід негайно викинути у смітник);
- не чіпайте брудними руками лиця, особливо очей, носа і рота.
4. Зміцнюйте імунітет:
- дотримуйтеся режиму здорового харчування: щодня їжте достатньо овочів і фруктів, продуктів з високим вмістом білка;
- багато пийте: воду, трав’яні чаї, натуральні соки;
- рухайтеся: регулярно займайтеся руховою активністю;
- лягайте спати завжди в один час і спіть не менше 7–8 годин на добу;
- мінімізуйте стрес за змоги — психологічне здоров'я має велике значення для імунної системи.
EU-JAMRAI 2 фінансується в рамках програми ЄС «EU4Health» (грантова угода № 101127787). Висловлені погляди та думки належать виключно автору(ам) і не обов'язково відображають позицію Європейського Союзу або Виконавчого агентства з питань охорони здоров'я та цифрових технологій (HaDEA). Європейський Союз та орган, що надає грант, не несуть відповідальності за зміст матеріалу.